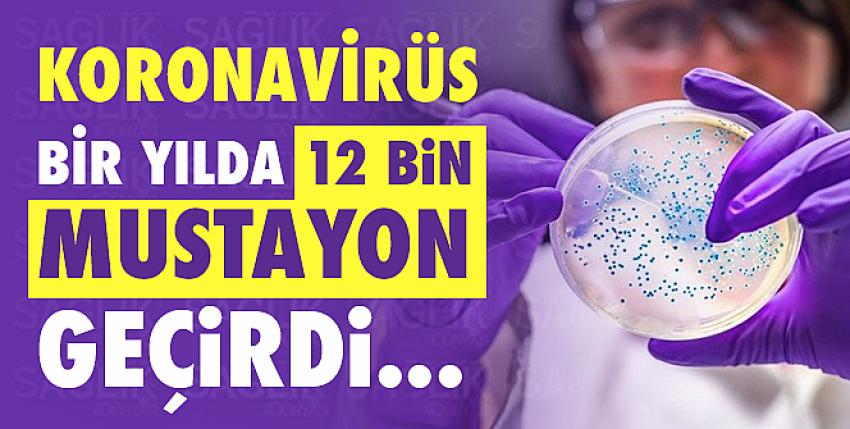

İstanbul Medeniyet Üniversitesi Tıp Fakültesi Dekanı Prof. Dr. Sadrettin Pençe, koronavirüsün Çin’de yapılan ilk tüm genom çalışmasının üzerinden geçen bir yıl içeri-sinde, virüste tam 12 bin mutasyon tespit edildiğini söyledi.
Koronavirüsün genetik haritasının ilk kez yayımlandığı 2020 Ocak ayından bu yana, tüm dünyada yapılan çalışmalar sonucu, virüs üzerinde yaklaşık 400 bin tüm genom sekansı yapıldı ve datalar National Center for Biotechnology Information veri bankasına eklendi.
İstanbul Medeniyet Üniversitesi (İMÜ) Tıp Fakültesi Dekanı ve Fizyoloji Ana Bilim Dalı Öğretim Üyesi Prof. Dr. Sadrettin Pençe, yapılan bu 400 bin genom dizilemesi ile virüste şimdiye dek 12 bin mutasyon tespit edildiğini ancak bunlardan birkaçının hastalığın seyrine veya bulaşıcılığına etki edecek düzeyde olduğunu söyledi.
Prof. Dr. Pençe, “Bu mutasyonların etkinliğinin olup olmadığı konusunda bir açıklama yapmak için fonksiyonel analiz yapmak gerekiyor. Birçok mutasyon, hastalığın gidişatına bir etkisi yok. Çok küçük ölçekli mutasyonlar bunlar. Burada, hastalığın şiddetini ve bulaşıcılığını artırıp artırmayla ilgili etkililik önem kazanıyor. Bugün itibariyle yeni mutasyonlardan bazılarının bulaşıcılığı artırdığı tespit edildi. İMÜ olarak bizim de geçtiğimiz aylarda yaptığımız tüm genom çalışması sonucu bulduğumuz D614 G mutasyonu tüm dünyada baskın durumdaydı. Şimdi İngiltere varyantı ön plana çıktı.” dedi.
“İNGİLTERE DÜNYADA EN FAZLA SEKANSLAMA YAPAN ÜLKE”
İngiltere varyantının bugün itibariyle dünyanın yüzde 80’inde baskın duruma geçtiğini belirten Prof. Dr. Pençe, “Bununla birlikte Güney Afrika mutasyonu ve Brezilya mutasyonu da ön plana çıktı. İngiltere, dünyada en çok virüs sekanslaması yapan ülke. Bu virüsü çok yakından takip ediyor. Onun için de İngiltere’den bu konuda çok fazla veri geliyor. İngiltere varyantının bulaşıcılığı artırdığı ancak hastalığın şiddetine bir etkinliğinin olmadığı açıklansa da bulaşma hızı arttığı için hastalanma riski de yükseldiği için ölümlerde de artış yaşanıyor. Güney Afrika varyantı ise hem İngiltere’deki mutasyonu içeriyor hem de Güney Afrika’daki mutasyonu içeriyor. Bu varyant, hem bulaşıcılığı artırıyor hem de hastalık şiddetini artırıyor. Brezilya varyantında da benzer bir durum var.” diye konuştu.
“HER BÖLGEDE FARKLI BİR MUTASYON GELİŞMİŞ OLABİLİR”
Mutasyonlarda en çok aşıların etkinliğinin azalmasından korkulduğuna da işaret eden Prof. Dr. Pençe, “Örneğin Amerika’da protein aşısı olarak geliştirilen bir aşının (Novavax), normal suşta yüzde 94 etkiliyken İngiltere varyantında etkisinin yüzde 80’lere düştüğü, olduğu Güney Afrika varyantında ise yüzde 50’lere gerilediği açıklandı” dedi. Türkiye’den de bu tür tüm genom çalışmalarının yani virüs sekanslamasının daha fazla sayıda yapılması gerektiğini de belirten Prof. Dr. Pençe, şu uyarılarda bulundu:
“Bu konuda da çalışıldığını biliyorum. Yakın zamanda Türkiye’den de bunların sonuçlarını göreceğiz. Türkiye giriş çıkışların çok olduğu bir ülke konumunda. Dolayısıyla her bölgede farklı mutasyonlar gelişebilir. Bunların tespit edilmesi lazım ve bu mutasyonların fonksiyonel analizlerinin de yapılması ve ‘Acaba bulaştırıcılığı artırıyor mu’, ‘Hastalığın şiddetine etki ediyor mu’ tespit edilmesi gerekiyor. Onun için bu çalışmalarının, yani tüm genom çalışmalarının birçok bölgede sıkça yapılması gerekiyor. Ülkemizde de birçok mutasyonlar oluyordur ancak bunların hastalığın şiddetine ve bulaşıcılığına ne denli etkili konusunda elimizde bir veri yok. Şu ana kadarki mutasyonların da bunu çok değiştirmediğini söyleyebiliriz.”
“PCR TESTLERİNDE ÇİTF GEN BÖLGESİ KULLANILMALI”
Bugünkü virüsün ilk çıktığı gündekinden çok farklı bir virüs olduğunu da vurgulayan Prof. Dr. Pençe, bu değişimlerin, virüs gen bölgelerine göre hastalığı teşhis edebilen PCR testleri üzerinde etkileri olabileceğini de söyleyerek, sözlerini şöyle noktaladı:
“12 bin tane mutasyon geçirip günümüze ulaşan virüs çok farklı bir durumda artık. Bu mutasyonların tabii ki PCR testlerine de etkisi olabilir. Şu andaki PCR testleri N geni, S geni ve orf1ab üzerinden virüsü tespit ediyor. Bu mutasyonlar ise daha çok N geni üzerinde. Orf1ab’de hiç yok, S geninde ise çok az oluyor. Dolayısıyla PCR testlerinin de tek gen üzerinden değil de en az iki gen üzerinden yaptığınızda yanılma oranı çok daha düşük. Tabii ki yeni mutasyonlara göre de PCR test primerlerinin yeniden dizayn edilmesi önemli. Bunları revize ederek PCR testlerini güncellemek gerekiyor.”(medimagazin)